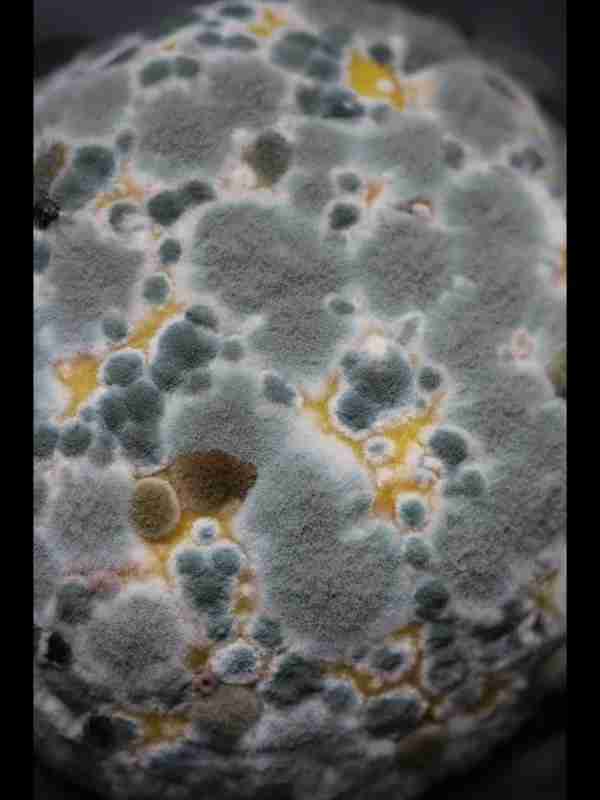

https://www.hsmcuae.ae/childrens-dental-treatment/
לְגַלוֹת פוסטים
https://www.hsmcuae.ae/root-canal-therapy/
https://www.hsmcuae.ae/teeth-whitening/
https://www.hsmcuae.ae/dental-veneers/
Culture Indoor | Hydrozone.fr
Transformez votre intérieur en un havre de verdure grâce à Hydrozone.fr. Apprenez à cultiver des plantes d'intérieur et à faire entrer l'extérieur à l'intérieur. Achetez dès aujourd'hui !
https://www.hydrozone.fr/12-chambre-box-culture

Guanokalong | Hydrozone.fr
Essayez les produits Guanokalong d'Hydrozone.fr et ressentez la puissance de la nature. Nos engrais organiques amélioreront le développement et la productivité de vos plantes. Achetez dès aujourd'hui !
https://www.hydrozone.fr/236-g....uanokalong-gk-organi

https://dikshaasharma.com/call-girls-in-jalandhar/
#****sserviceinjalandhar
#jalandhar****sservices
#jalandhar****s
#****sinjalandhar
#callgirlsinjalandhar
#jalandharcallgirlsservice
#callgirlsserviceinjalandhar

NDIS Plan Management Provider Sydney | Healthassure.com.au
Access reliable NDIS plan management services in Sydney with Healthassure.com.au. As a leading NDIS Plan Management Provider Sydney, we offer expert budgeting, provider coordination, and personalized support.
https://www.healthassure.com.au/partners-providers